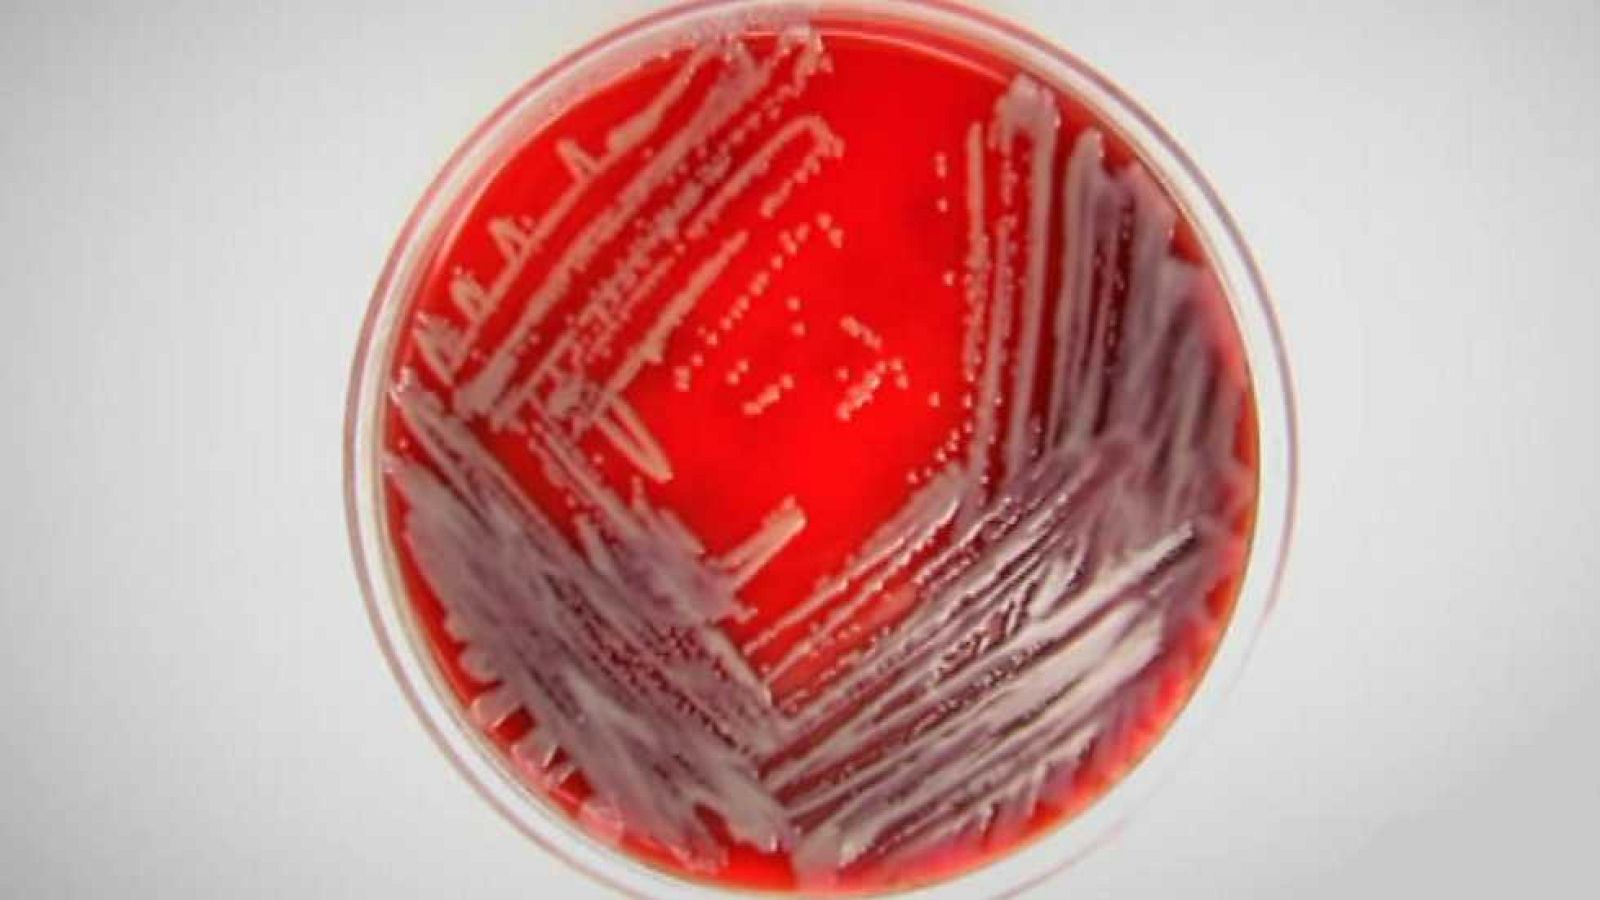
Documentos TV - Una bacteria de pesadilla - ver ahora

Documentos TV. "Bacteria de pesadilla"
- El abuso de antibióticos ha provocado la aparición de superbacterias
- Estos organismos, resistentes a la penicilina, son toda una amenaza sanitaria
- Los expertos calculan que cada año infectan a unos dos millones de personas
- El desinterés de la industria y la limitada investigación agravan el problema
- Una bacteria de pesadilla se emitió el 6 de julio de 2015 en La 2
Ver ahora
Ver ahoraSe sabe de ellas desde hace poco más de una década. Sus nombres de pila responden a NDM1, Gram negativas y KPC, aunque se las conoce por el término común de superbacterias. Preocuparon al colectivo médico porque no existían tratados clínicos sobre su tratamiento y en especial por su “modus operandi”. Consiguen que infecciones tratables dejen de serlo de repente porque estos organismos son resistentes a los antibióticos convencionales.

Los antibióticos son uno de los milagros de la medicina moderna. Sin embargo, su abuso está ayudando a crear bacterias muy peligrosas
Asimilar que podemos morir de una infección
Una bacteria de pesadilla es el relato de tres casos no relacionados que tienen un mismo denominador común: una infección imposible de tratar, cuyo recorrido finaliza en un trasplante de pulmón, en una amputación de pierna o, en el más trágico de los casos, en la muerte.
Hemos olvidado la advertencia que el propio Fleming hizo en 1945
Lo más difícil para nuestra sociedad, que ha dispuesto de antibióticos desde el final de la Segunda Guerra Mundial, es asimilar que podemos morir a causa de una infección. El abuso de estos medicamentos ha originado que las bacterias se hagan resistentes a ellos. “Hemos olvidado la advertencia que el propio Fleming hizo en 1945: “Cuanta más penicilina se emplee, más personas morirán de infecciones resistentes a ella”, recuerda un experto médico en el documental.

Fleming, el primero en observar los efectos antibióticos de la penicilina.
Si a este problema le añadimos la renuncia de la industria farmacéutica a desarrollar nuevos antibióticos por razones de rentabilidad, nos situamos en un escenario de vulnerabilidad frente a unas superbacterias que han colonizado ya espacios más allá de los hospitales.
Investigación limitada
Al menos dos millones de personas se infectan cada año con bacterias resistentes
Los especialistas calculan, que al menos dos millones de personas se infectan cada año con bacterias resistentes a los antibióticos convencionales y algo más de 20.000 fallecen a causa de las infecciones, más muertes que las que provoca el Sida.

Documentación médica de un paciente fallecido por infección con superbacteria KPC
Los médicos alertan de la limitada investigación sobre nuevos antibióticos lo que significa que, probablemente, estamos llegando al final de la práctica médica con estos medicamentos.
Una bacteria de pesadilla se emitió en Documentos TV el lunes 6 de julio de 2015 en La 2.